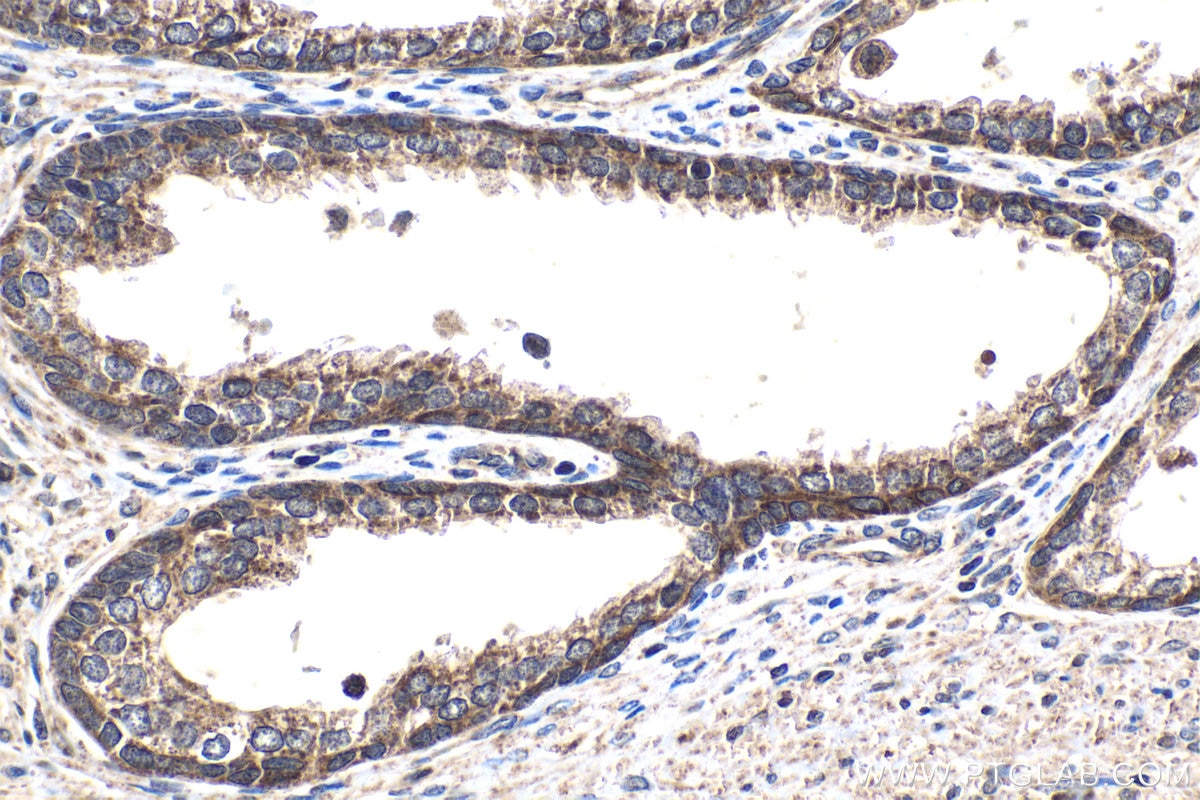
Immunohistochemistry (IHC) staining of human prostate cancer tissue using SMAD9 Polyclonal antibody (16397-1-AP)

Tested Applications
| Positive WB detected in | HeLa cells, A549 cells, HEK-293 cells, HepG2 cells, mouse lung tissue |
| Positive IHC detected in | human prostate cancer tissue, human urothelial carcinoma tissue, mouse heart tissue, rat heart tissue Note: suggested antigen retrieval with TE buffer pH 9.0; (*) Alternatively, antigen retrieval may be performed with citrate buffer pH 6.0 |
Recommended dilution
| Application | Dilution |
|---|---|
| Western Blot (WB) | WB : 1:500-1:2000 |
| Immunohistochemistry (IHC) | IHC : 1:50-1:500 |
| It is recommended that this reagent should be titrated in each testing system to obtain optimal results. | |
| Sample-dependent, Check data in validation data gallery. | |
Published Applications
| WB | See 4 publications below |
Product Information
16397-1-AP targets SMAD9 in WB, IHC, ELISA applications and shows reactivity with human, mouse, rat samples.
| Tested Reactivity | human, mouse, rat |
| Cited Reactivity | human, mouse |
| Host / Isotype | Rabbit / IgG |
| Class | Polyclonal |
| Type | Antibody |
| Immunogen |
CatNo: Ag9490 Product name: Recombinant human SMAD9 protein Source: e coli.-derived, PGEX-4T Tag: GST Domain: 1-352 aa of BC011559 Sequence: MHSTTPISSLFSFTSPAVKRLLGWKQGDEEEKWAEKAVDSLVKKLKKKKGAMDELERALSCPGQPSKCVTIPRSLDGRLQVSHRKGLPHVIYCRVWRWPDLQSHHELKPLECCEFPFGSKQKEVCINPYHYRRVETPVLPPVLVPRHSEYNPQLSLLAKFRSASLHSEPLMPHNATYPDSFQQPPCSALPPSPSHAFSQSPCTASYPHSPGSPSEPESPYQHSDFRPVCYEEPQHWCSVAYYELNNRVGETFQASSRSVLIDGFTDPSNNRNRFCLGLLSNVNRNSTIENTRRHIGKGVHLYYVGGEVYAECVSDSSIFVQSRNCNYQHGFHPATVCKIPSGCSLKVFNNQL Predict reactive species |
| Full Name | SMAD family member 9 |
| Calculated Molecular Weight | 430 aa, 49 kDa |
| Observed Molecular Weight | 49-55 kDa |
| GenBank Accession Number | BC011559 |
| Gene Symbol | SMAD9 |
| Gene ID (NCBI) | 4093 |
| RRID | AB_2270847 |
| Conjugate | Unconjugated |
| Form | Liquid |
| Purification Method | Antigen affinity purification |
| UNIPROT ID | O15198 |
| Storage Buffer | PBS with 0.02% sodium azide and 50% glycerol, pH 7.3. |
| Storage Conditions | Store at -20°C. Stable for one year after shipment. Aliquoting is unnecessary for -20oC storage. 20ul sizes contain 0.1% BSA. |
Background Information
SMAD9 (also known as MADH9 or MAD homolog 9) is a key signaling molecule in the transforming growth factor-β (TGF-β) superfamily signaling pathway and belongs to the SMAD1/5/9 subgroup of receptor-regulated SMADs (R-SMADs). It is primarily activated and phosphorylated by BMP (bone morphogenetic protein) type I receptors. Once activated, SMAD9 forms a complex with the common SMAD4 (Co-SMAD), translocates into the nucleus, and acts as a transcription factor to regulate the expression of specific target genes. This process is involved in modulating a variety of critical biological processes, including cell proliferation, differentiation, apoptosis, and embryonic development. Mutations or abnormal expression of SMAD9 are associated with several diseases, particularly in pulmonary arterial hypertension, certain cancers, and vascular diseases, where it plays a significant role.
Protocols
| Product Specific Protocols | |
|---|---|
| IHC protocol for SMAD9 antibody 16397-1-AP | Download protocol |
| WB protocol for SMAD9 antibody 16397-1-AP | Download protocol |
| Standard Protocols | |
|---|---|
| Click here to view our Standard Protocols |
Publications
| Species | Application | Title |
|---|---|---|
IUBMB Life LncRNA RP11-301G19.1 is required for the maintenance of vascular smooth muscle cell contractile phenotype via sponging miR-17-5P/ATOH8 axis | ||
Sci Rep Schisandrin B regulates MC3T3-E1 subclone 14 cells proliferation and differentiation through BMP2-SMADs-RUNX2-SP7 signaling axis. | ||
Cell Death Discov Gsα deficiency facilitates cardiac remodeling via CREB/ Bmp10-mediated signaling | ||
Bioact Mater A tantalum-containing zirconium-based metallic glass with superior endosseous implant relevant properties |
Reviews
The reviews below have been submitted by verified Proteintech customers who received an incentive for providing their feedback.
FH Nadia (Verified Customer) (09-15-2025) | We used this SMAD9 antibody for both Western blot and immunofluorescence applications. The antibody produced a clear, specific band with minimal background.
|